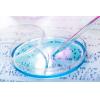

Una ricerca del Centro Nazionale per la Ricerca Cardiovascolare Carlo III di Madrid ha trovato la ricetta dell’invecchiare in buona salute. Longevità e vecchiaia serena sono il frutto dell’equilibrio tra il Dna del nucleo cellulare e...
Leggi tutto...La longevità nasce da un mix di Dna